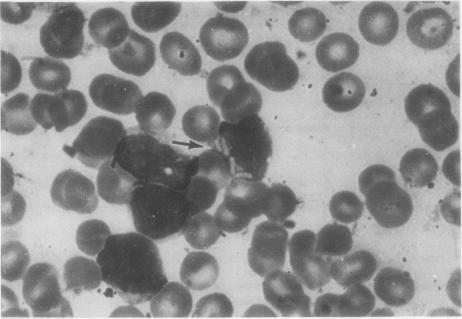
https://cdn.ncbi.nlm.nih.gov/pmc/blobs/f110/1145238/ae1677897a09/jclinpath00439-0052-a.jpg
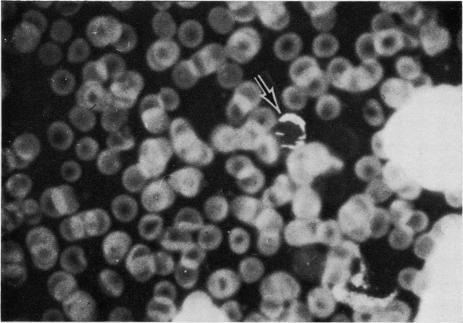
https://cdn.ncbi.nlm.nih.gov/pmc/blobs/f110/1145238/636ea0f64bba/jclinpath00439-0053-a.jpg

三例免疫细胞瘤中的IgM λ胞质晶体:一项临床、细胞化学及超微结构研究
IgM lambda cytoplasmic crystals in three cases of immunocytoma: a clinical, cytochemical, and ultrastructural study.
作者信息
Feremans W W, Neve P, Caudron M
出版信息
J Clin Pathol. 1978 Mar;31(3):250-8. doi: 10.1136/jcp.31.3.250.
Endoplasmic reticulum-associated crystals were seen in 1-10% of the bone-marrow lymphocytes and in the lymphocytes of the peripheral blood in three cases of immunocytoma. Their crystalline nature and their location in the cisternae of the rough endoplasmic reticulum was proved by ultrastructural study. IgM lambda in the crystals was demonstrated by fluorescent and peroxidase-labelled antibody methods. The crystals did not stain with the PAS reaction, suggesting that the immunoglobulin was not bound to a carbohydrate group. A defect in glucosyltransferase activity with failure to modify the immunoglobulins could explain the absence of the PAS reaction and the accumulation of immunoglobulin in crystalline before reaching the Golgi region.
在3例免疫细胞瘤中,1% - 10%的骨髓淋巴细胞和外周血淋巴细胞内可见内质网相关晶体。超微结构研究证实了其晶体性质及其位于粗面内质网池内的位置。通过荧光和过氧化物酶标记抗体法证实晶体中存在IgMλ。晶体对PAS反应不着色,提示免疫球蛋白未与碳水化合物基团结合。葡萄糖基转移酶活性缺陷导致免疫球蛋白修饰失败,这可以解释PAS反应阴性以及免疫球蛋白在到达高尔基体区域之前以晶体形式积聚的现象。